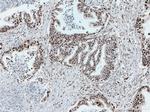
SUB1 Antibody in Immunohistochemistry (Paraffin) (IHC (P))

Search
Proteintech
SUB1 Polyclonal Antibody
{{$productOrderCtrl.translations['antibody.pdp.commerceCard.promotion.promotions']}}
{{$productOrderCtrl.translations['antibody.pdp.commerceCard.promotion.viewpromo']}}
{{$productOrderCtrl.translations['antibody.pdp.commerceCard.promotion.promocode']}}: {{promo.promoCode}} {{promo.promoTitle}} {{promo.promoDescription}}. {{$productOrderCtrl.translations['antibody.pdp.commerceCard.promotion.learnmore']}}
产品信息
10948-2-AP
种属反应
已发表种属
宿主/亚型
分类
类型
抗原
偶联物
形式
浓度
规格
纯化类型
保存液
内含物
保存条件
运输条件
产品详细信息
This antibody recognize 14-16 kDa (P14 or P15), 20 kDa (phospho form) and 30 kDa (Dimer form).
Immunogen sequence: MPKSKELVS SGSSGSDSDS EVDKKLKRKK QVAPEKPVKK QKTGETSRAL SSSKQSSSSR DDNMFQIGKM RYVSVRDFKG KVLIDIREYW MDPEGEMKPG RKGISLNPEQ WSQLKEQISD IDDAVRKL (1-127 aa encoded by BC009610)
靶标信息
PC4 (activated RNA polymerase II transcription cofactor 4) is a transcriptional coactivator, possessing the ability to suppress promoter-driven as well as nonspecific transcription via its DNA binding activity. The repressive activity of PC4 on promoter-driven transcription is alleviated by transcription factor TFIIH. TFIIH protects promoters from PC4-mediated repression by relieving the topological constraint imposed by PC4 through the ERCC3 helicase activity.
仅用于科研。不用于诊断过程。未经明确授权不得转售。
生物信息学
蛋白别名: activated RNA polymerase II transcription cofactor 4; Activated RNA polymerase II transcriptional coactivator p15; p14; PC4; Positive cofactor 4; pR-ET2 encoded oncodevelopmental protein; RNA polymerase II transcriptional coactivator; Single-stranded DNA-binding protein p9; SUB1 homolog; SUB1 homolog, transcriptional regulator; TIS7; unnamed protein product
基因别名: AI842364; p14; P15; P9; PC4; RPO2TC1; SUB1
UniProt ID: (Human) P53999, (Rat) Q63396, (Mouse) P11031
Entrez Gene ID: (Human) 10923, (Rat) 192269, (Mouse) 20024